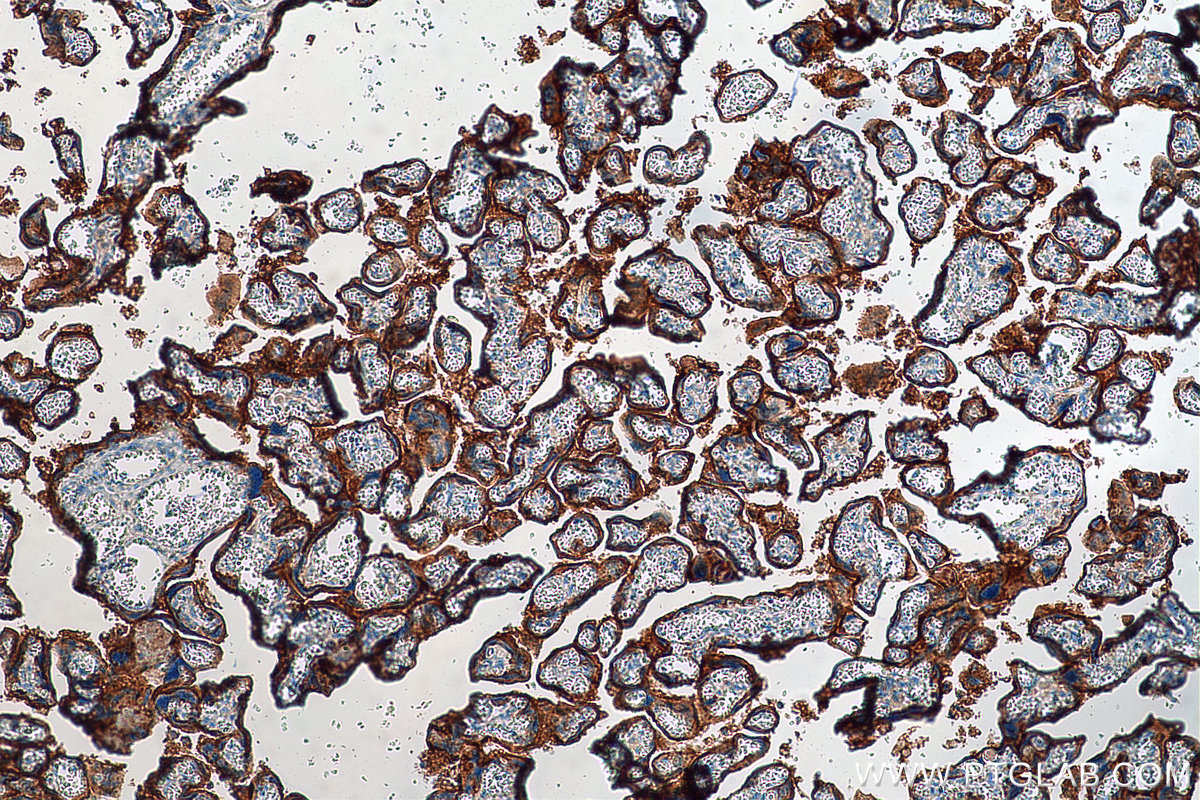

验证数据展示
经过测试的应用
| Positive WB detected in | IFN gamma treated A549 cells, human placenta tissue, MDA-MB-231 cells, mouse heart tissue, rat heart tissue, THP-1 cells |
| Positive IP detected in | MDA-MB-231 cells |
| Positive IHC detected in | human tonsillitis tissue, human placenta tissue, human breast cancer tissue, human lung cancer tissue, human cervical cancer tissue Note: suggested antigen retrieval with TE buffer pH 9.0; (*) Alternatively, antigen retrieval may be performed with citrate buffer pH 6.0 |
| Positive IF-P detected in | human tonsillitis tissue, human placenta tissue |
推荐稀释比
| 应用 | 推荐稀释比 |
|---|---|
| Western Blot (WB) | WB : 1:1000-1:6000 |
| Immunoprecipitation (IP) | IP : 0.5-4.0 ug for 1.0-3.0 mg of total protein lysate |
| Immunohistochemistry (IHC) | IHC : 1:500-1:2000 |
| Immunofluorescence (IF)-P | IF-P : 1:50-1:500 |
| It is recommended that this reagent should be titrated in each testing system to obtain optimal results. | |
| Sample-dependent, Check data in validation data gallery. | |
产品信息
28076-1-AP targets PD-L1/CD274 (C-terminal) in WB, IHC, IF-P, IP, CoIP, ChIP, ELISA applications and shows reactivity with human, mouse, rat samples.
| 经测试应用 | WB, IHC, IF-P, IP, ELISA Application Description |
| 文献引用应用 | WB, IHC, IF, IP, CoIP, ChIP, ELISA |
| 经测试反应性 | human, mouse, rat |
| 文献引用反应性 | human, mouse, rat, canine |
| 免疫原 |
CatNo: Ag27557 Product name: Recombinant human PD-L1/CD274 protein Source: e coli.-derived, PGEX-4T Tag: GST Domain: 181-290 aa of BC074984 Sequence: TTNSKREEKLFNVTSTLRINTTTNEIFYCTFRRLDPEENHTAELVIPELPLAHPPNERTHLVILGAILLCLGVALTFIFRLRKGRMMDVKKCGIQDTNSKKQSDTHLEET 种属同源性预测 |
| 宿主/亚型 | Rabbit / IgG |
| 抗体类别 | Polyclonal |
| 产品类型 | Antibody |
| 全称 | CD274 molecule |
| 别名 | CD274, PD-L1, B7 H1, B7-H1, hPD-L1 |
| 计算分子量 | 290 aa, 33 kDa |
| 观测分子量 | 45-50 kDa |
| GenBank蛋白编号 | BC074984 |
| 基因名称 | PD-L1 |
| Gene ID (NCBI) | 29126 |
| RRID | AB_2881052 |
| 偶联类型 | Unconjugated |
| 形式 | Liquid |
| 纯化方式 | Antigen affinity purification |
| UNIPROT ID | Q9NZQ7 |
| 储存缓冲液 | PBS with 0.02% sodium azide and 50% glycerol, pH 7.3. |
| 储存条件 | Store at -20°C. Stable for one year after shipment. Aliquoting is unnecessary for -20oC storage. |
背景介绍
PD-L1, also known as CD274 or B7H1, stands for programmed cell death ligand 1. It is a type I transmembrane protein that is thought to repress immune responses by binding to its receptor (PD1), thus inhibiting T-cell activation, proliferation, and cytokine production. It contains V-like and C-like immunoglobulin domains. PD-L1 expression is regulated by various cytokines, such as TNF-α or LPS (ISSN: 1848-7718). Increased expression of this protein in certain types of cancers, e.g., renal cell carcinoma or colon cancer, correlates with poor prognosis.
What is the molecular weight of PD-L1?
Depending on the isoform, the calculated molecular weight of the protein varies between 20 and 33 kDa (176-290 aa).
What are the isoforms of PD-L1?
According to NCBI, three different isoforms have been identified. There are significant differences in the untranslated and protein coding regions.
What is the subcellular localization and tissue specificity of PD-L1?
It is predicted to localize in the plasma membrane of various cell types, with a particularly high expression in placental trophoblast and subsets of immune cells. High levels of PD-L1 protein have also been detected in lung and colon tissues.
What is the function of PD-L1 in immune responses?
PD-L1 is critical for the induction and maintenance of immune self-tolerance during infection or inflammation in normal tissues. The interaction of PD-L1 and its receptors is responsible for preventing auto-immune phenotypes and balancing the overall immune response in situations such as pregnancy or tissue allografts. The interaction between PD-L1 and PD-1 or B7.1 starts an inhibitory signaling cascade, which results in the decreased proliferation of antigen-specific T-cells and increased survival of regulatory T-cells (PMID: 15240681).
How can PD-L1's implication in cancer be used as a drug target?
In certain tumors, high expression of PD-L1 serves as a stop-sign to inhibit the recognition of cancer cells by T-cells (PMID: 23087408). The interaction between PD-L1 and its receptors (PD1 and B7.1) is a mechanism for the tumor to evade the host immune response (PMID: 29357948). Several mAbs have been developed to target that interaction and thus prevent the inactivation of cytotoxic T-cells by the tumor (PMIDs: 23890059, 18173375).
实验方案
| Product Specific Protocols | |
|---|---|
| IF protocol for PD-L1/CD274 (C-terminal) antibody 28076-1-AP | Download protocol |
| IHC protocol for PD-L1/CD274 (C-terminal) antibody 28076-1-AP | Download protocol |
| IP protocol for PD-L1/CD274 (C-terminal) antibody 28076-1-AP | Download protocol |
| WB protocol for PD-L1/CD274 (C-terminal) antibody 28076-1-AP | Download protocol |
| Standard Protocols | |
|---|---|
| Click here to view our Standard Protocols |
发表文章
| Species | Application | Title |
|---|---|---|
Mol Cancer Targeting PERP promotes anti-tumor immunity in HNSCC by regulating tumor immune microenvironment and metabolic homeostasis | ||
Cell Metab Dual impacts of serine/glycine-free diet in enhancing antitumor immunity and promoting evasion via PD-L1 lactylation | ||
ACS Cent Sci Allosteric Regulation of IGF2BP1 as a Novel Strategy for the Activation of Tumor Immune Microenvironment | ||
Nat Commun A protease-cleavable liposome for co-delivery of anti-PD-L1 and doxorubicin for colon cancer therapy in mice | ||
Cell Rep Med Benzosceptrin C induces lysosomal degradation of PD-L1 and promotes antitumor immunity by targeting DHHC3 | ||
Sci Adv Inhibition of ACLY overcomes cancer immunotherapy resistance via polyunsaturated fatty acids peroxidation and cGAS-STING activation |